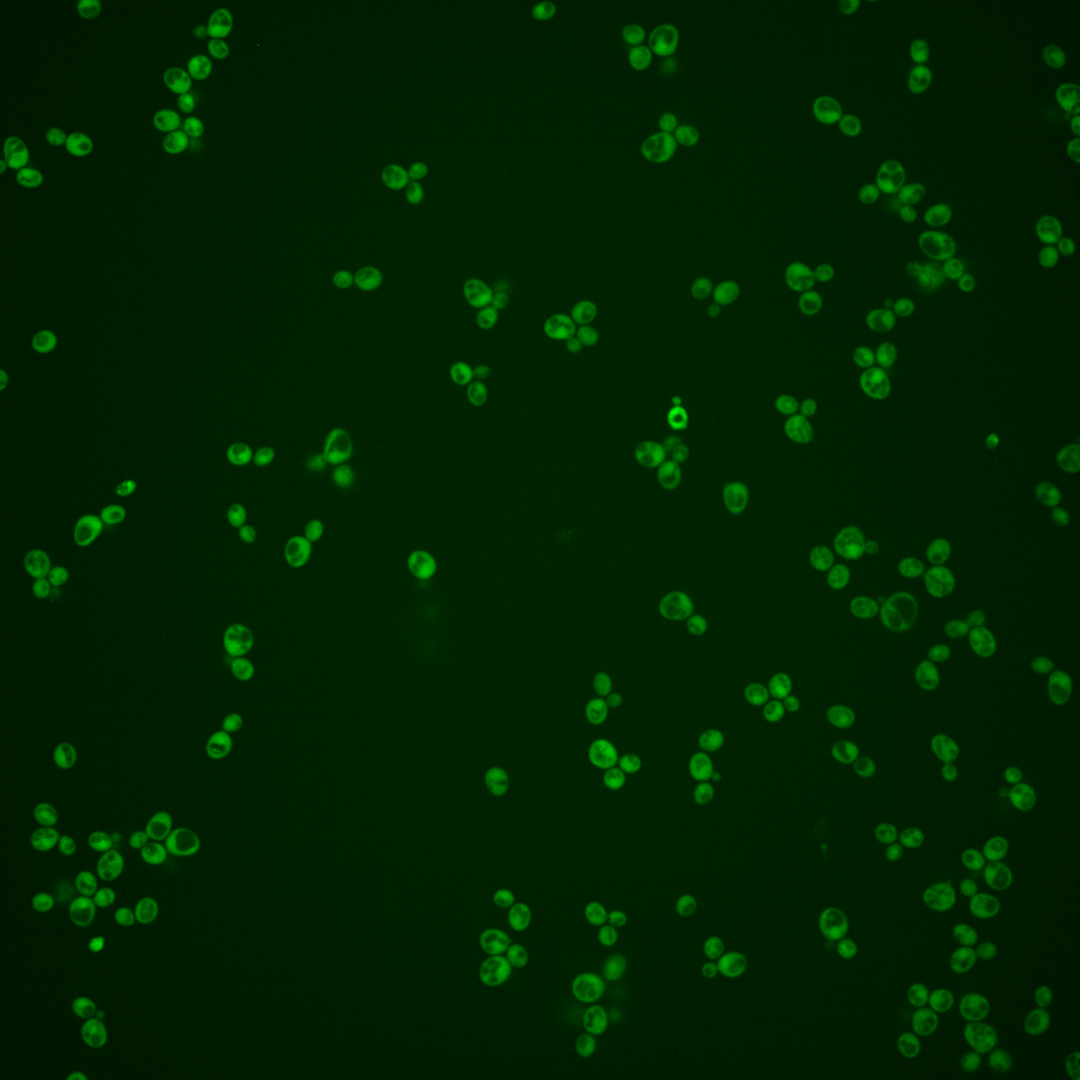
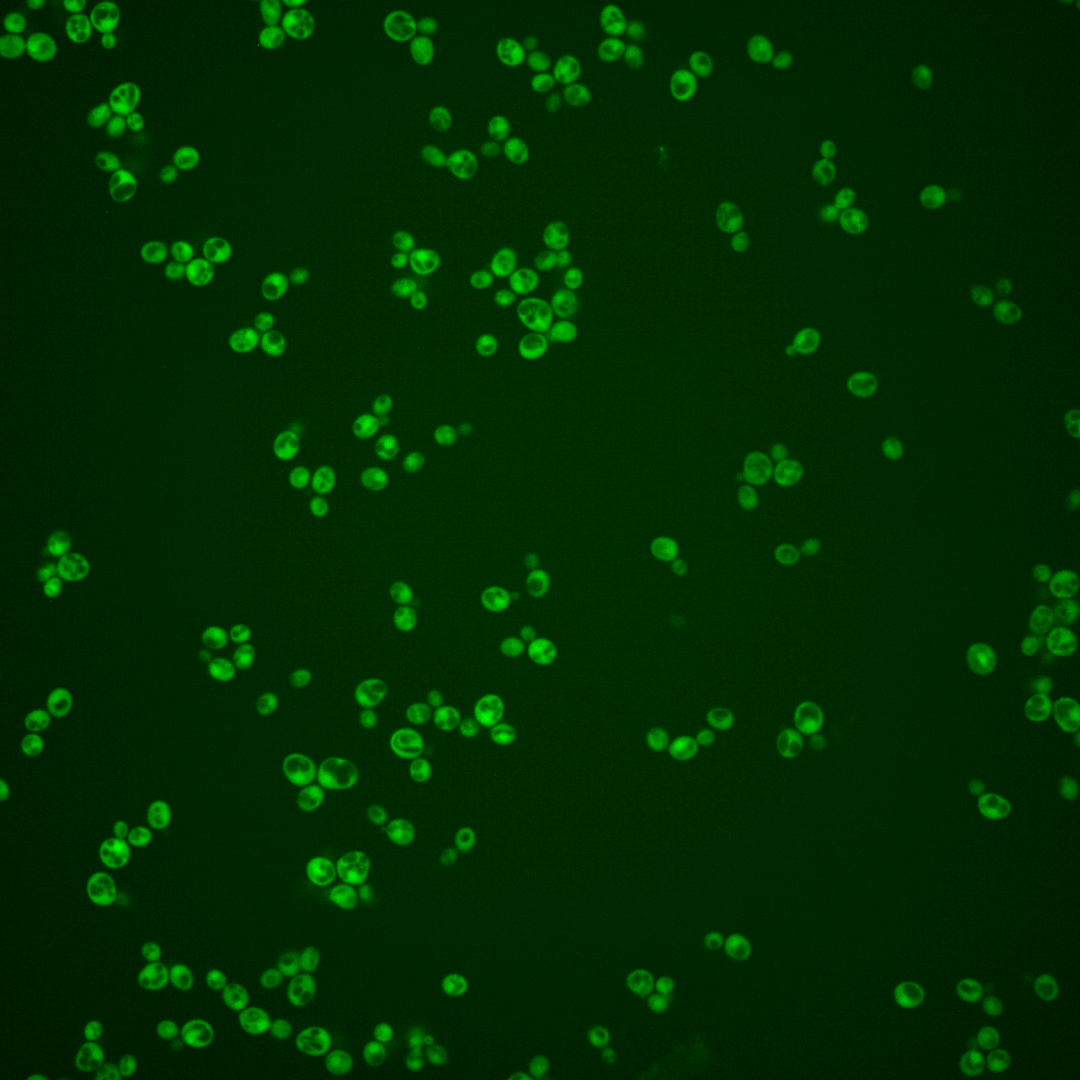
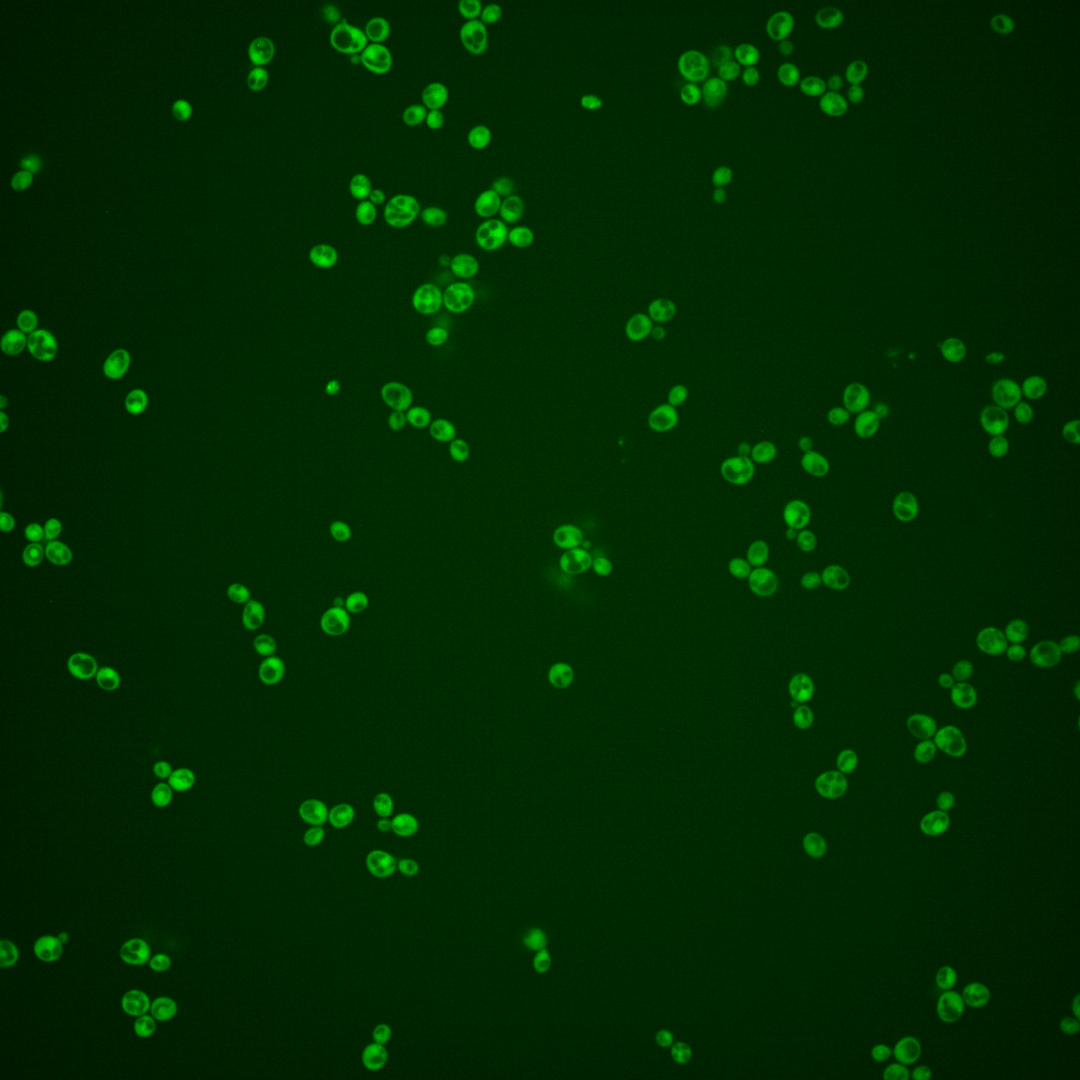
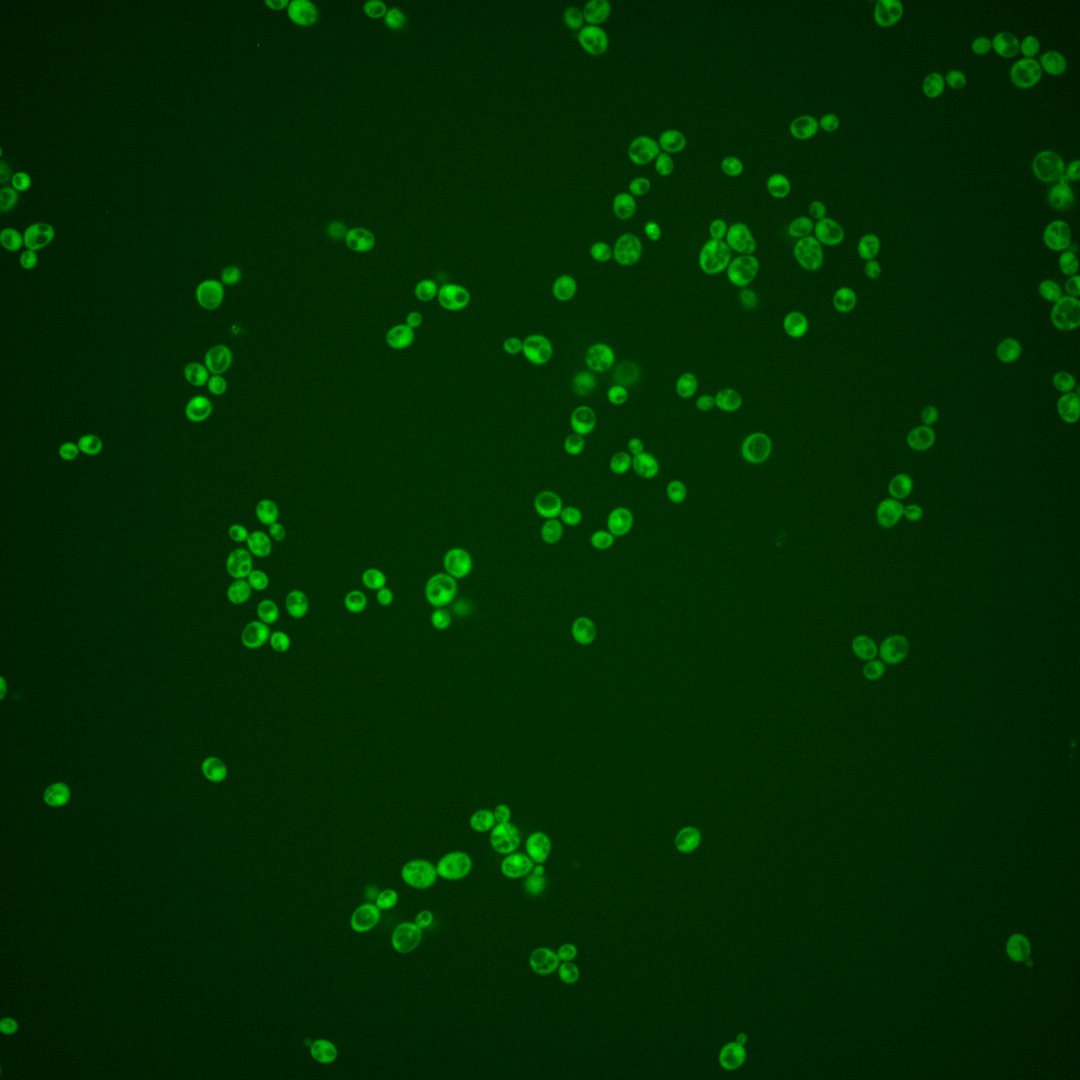
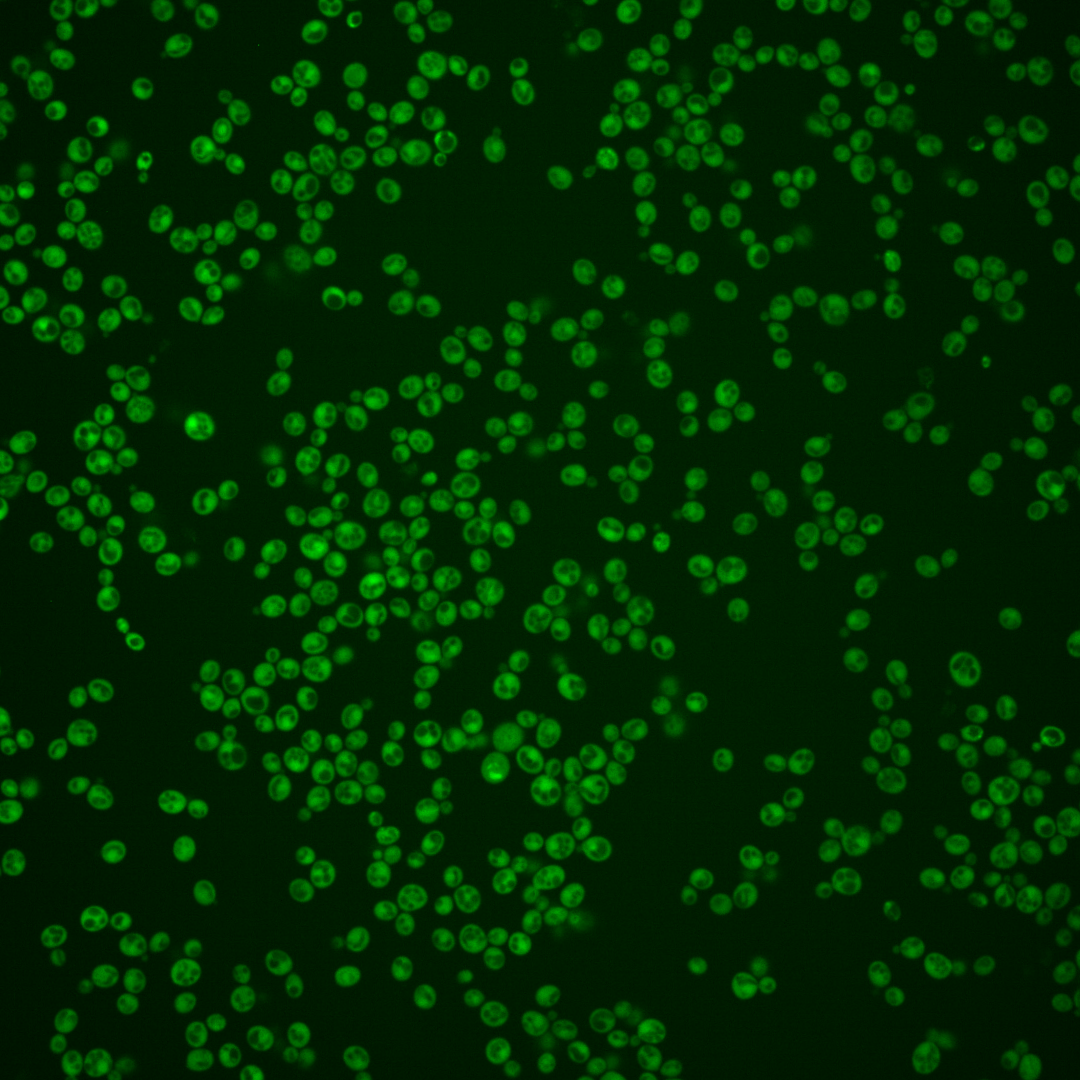
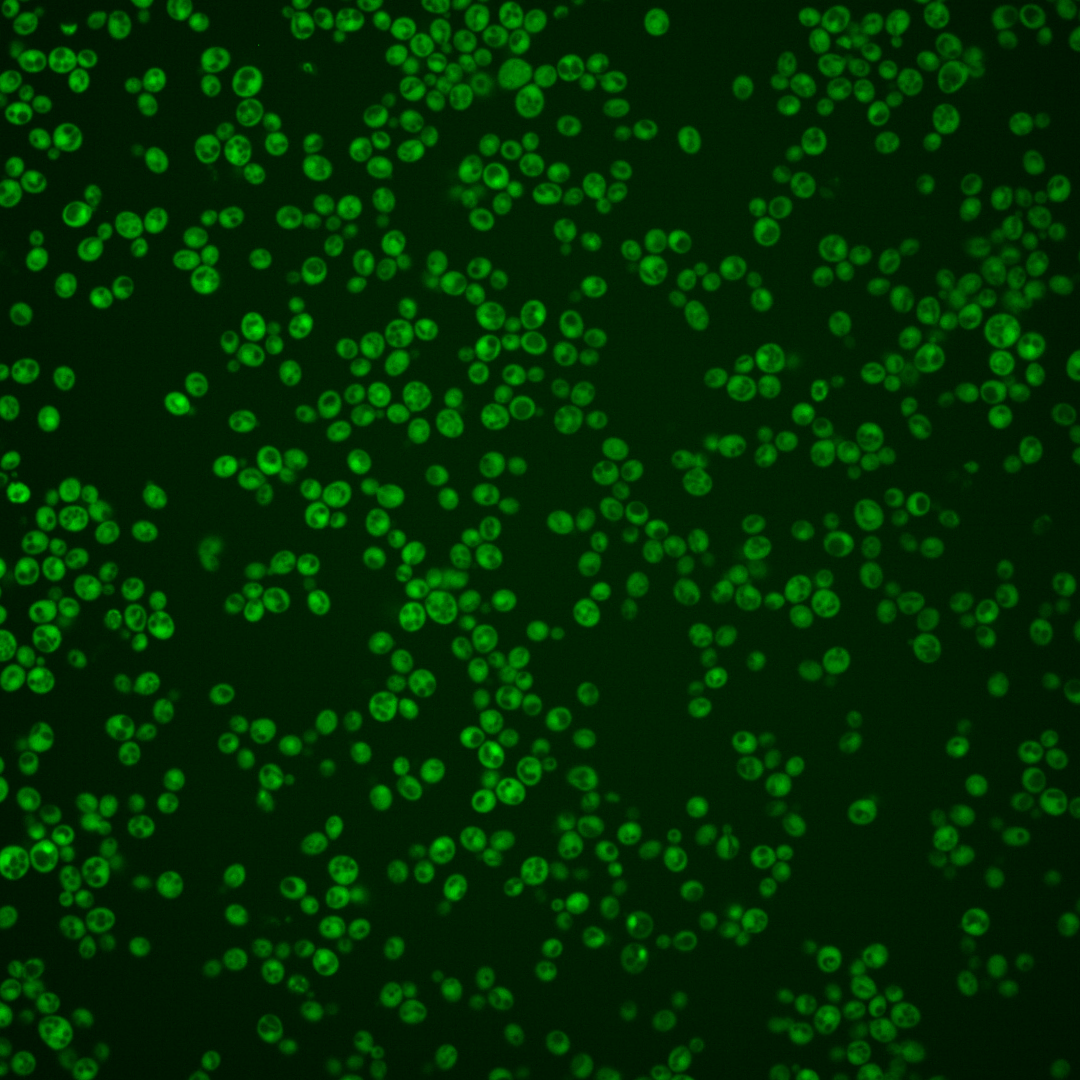
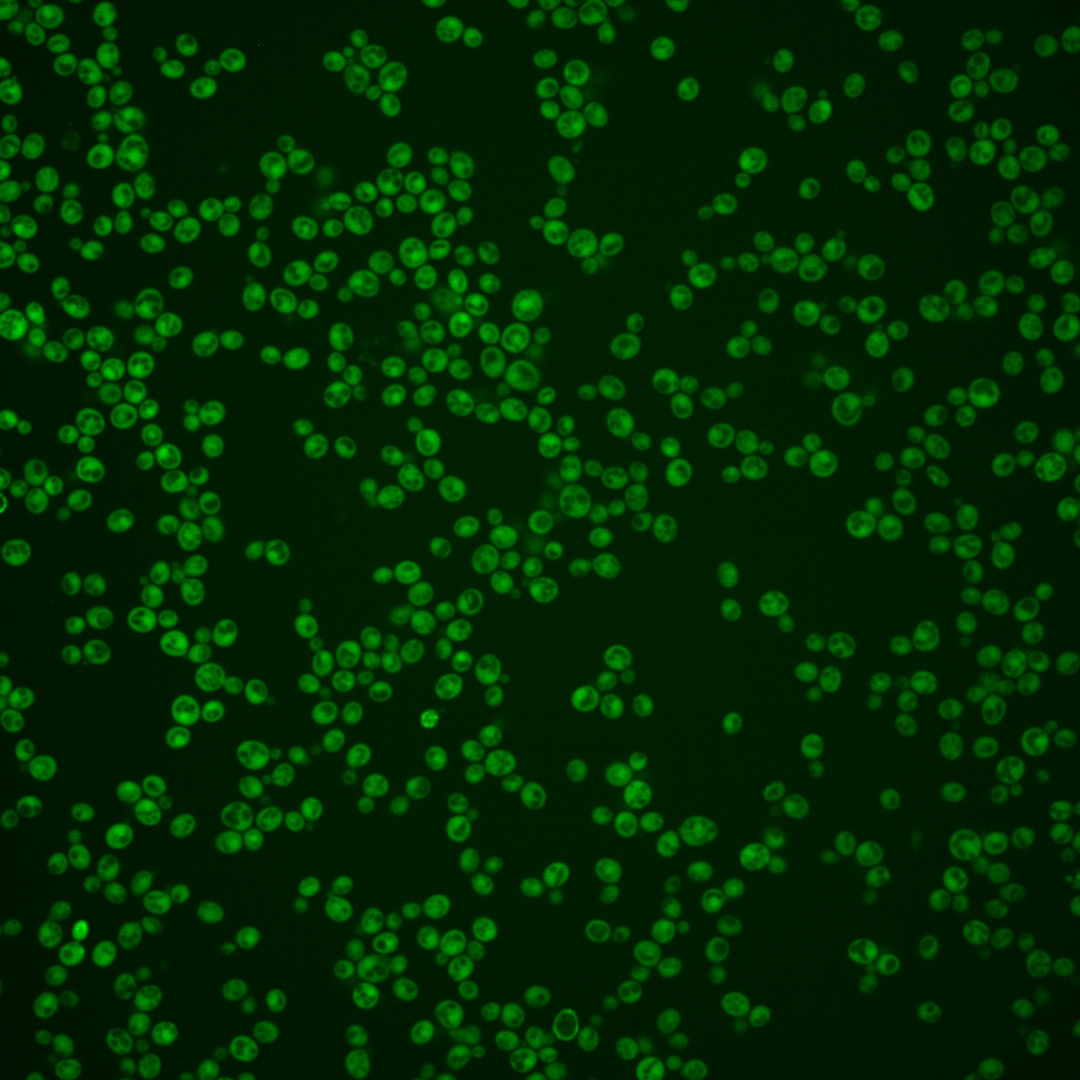
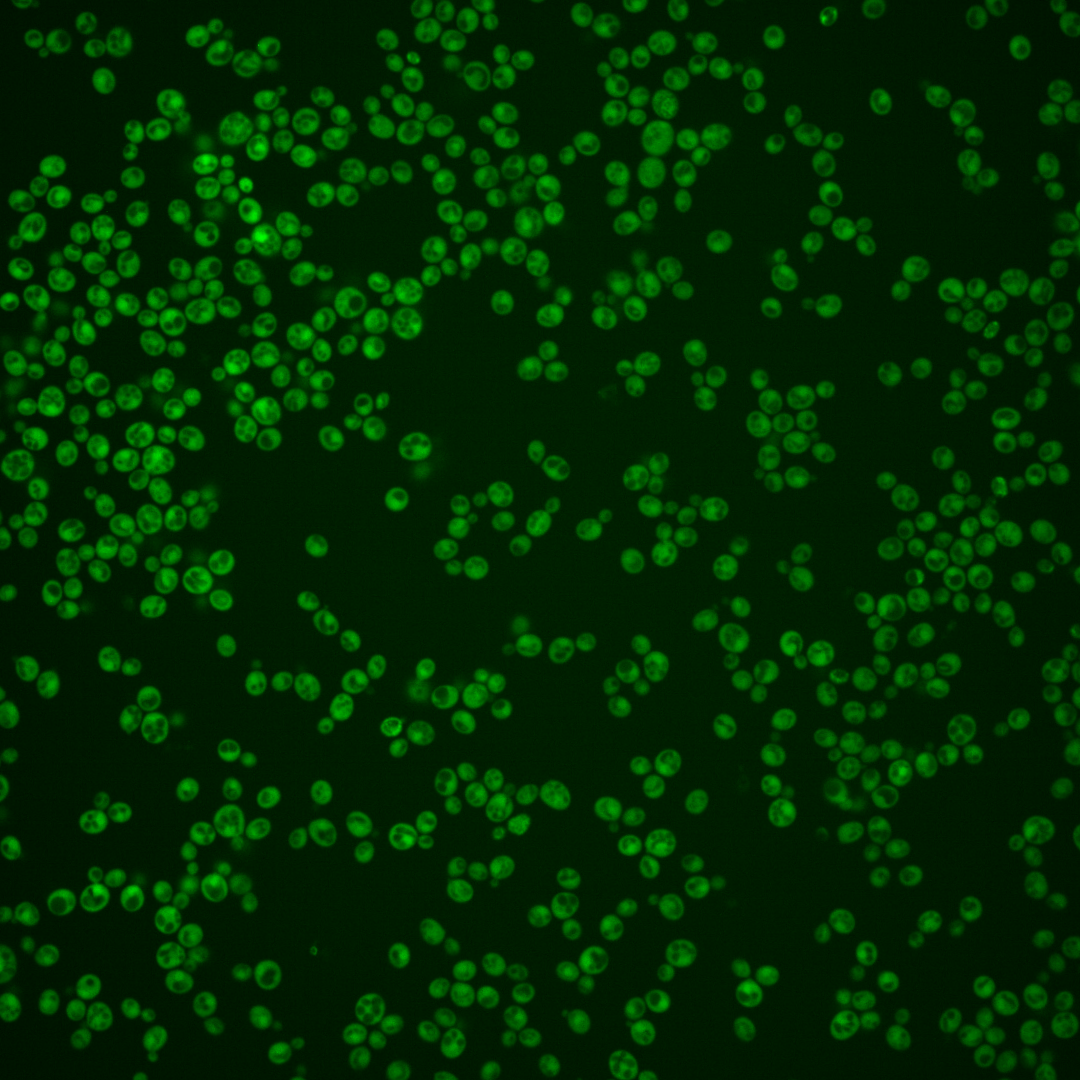

| ORF | |
|---|---|
| Human Ortholog | |
| Description | Methionine-R-sulfoxide reductase; reduces the R enantiomer of free Met-SO, in contrast to Ycl033Cp which reduces Met-R-SO in a peptide linkage; has a role in protection against oxidative stress; relative distribution to the nucleus increases upon DNA replication stress |
Micrographs




















































































Sub-cellular Localization
Yeast GFP Assignment
Protein Abundance
Localization Change
External localization resources
| ensLOC | DeepLoc | |||||||||||||||||||||||
|---|---|---|---|---|---|---|---|---|---|---|---|---|---|---|---|---|---|---|---|---|---|---|---|---|
| Localization | WT1 | WT2 | WT3 | RAP60 | RAP140 | RAP220 | RAP300 | RAP380 | RAP460 | RAP540 | RAP620 | RAP700 | HU80 | HU120 | HU160 | rpd3Δ_1 | rpd3Δ_2 | rpd3Δ_3 | WT1 | WT2 | WT3 | AF100 | AF140 | AF180 |
| Cortical Patches | 0 | 0 | 0 | 0 | 0 | 0 | 0 | – | 0 | 2 | 0 | 3 | 0 | 0 | 0 | 0 | 1 | 0 | 1 | 0 | 2 | 0 | 4 | 2 |
| Bud | 0 | 0 | 1 | 0 | 0 | 2 | 1 | – | 3 | 1 | 1 | 5 | 0 | 0 | 0 | 0 | 0 | 0 | 1 | 1 | 0 | 0 | 4 | 9 |
| Bud Neck | 0 | 0 | 0 | 0 | 0 | 0 | 0 | – | 0 | 0 | 0 | 0 | 0 | 0 | 0 | 0 | 0 | 0 | 0 | 0 | 0 | 0 | 0 | 2 |
| Bud Site | 0 | 0 | 0 | 0 | 0 | 0 | 0 | – | 0 | 0 | 0 | 0 | 0 | 0 | 0 | 0 | 0 | 0 | – | – | – | – | – | – |
| Cell Periphery | 2 | 0 | 2 | 2 | 4 | 0 | 11 | – | 3 | 11 | 5 | 13 | 0 | 0 | 1 | 2 | 2 | 4 | 0 | 0 | 0 | 0 | 0 | 0 |
| Cytoplasm | 508 | 164 | 287 | 257 | 288 | 332 | 433 | – | 306 | 324 | 406 | 331 | 480 | 523 | 710 | 112 | 120 | 90 | 497 | 152 | 274 | 335 | 531 | 482 |
| Endoplasmic Reticulum | 3 | 1 | 4 | 0 | 0 | 1 | 1 | – | 5 | 5 | 4 | 13 | 3 | 4 | 1 | 6 | 1 | 4 | 2 | 0 | 1 | 1 | 7 | 7 |
| Endosome | 0 | 0 | 0 | 0 | 1 | 1 | 1 | – | 0 | 1 | 1 | 1 | 0 | 0 | 0 | 14 | 7 | 6 | 1 | 0 | 2 | 1 | 36 | 50 |
| Golgi | 0 | 0 | 1 | 0 | 0 | 0 | 0 | – | 0 | 0 | 0 | 0 | 0 | 0 | 1 | 4 | 1 | 0 | 2 | 0 | 0 | 1 | 12 | 22 |
| Mitochondria | 1 | 0 | 0 | 1 | 0 | 33 | 12 | – | 53 | 46 | 86 | 91 | 1 | 0 | 0 | 4 | 1 | 2 | 1 | 1 | 3 | 0 | 1 | 3 |
| Nucleus | 3 | 0 | 2 | 6 | 3 | 8 | 15 | – | 23 | 8 | 28 | 25 | 6 | 2 | 2 | 5 | 0 | 1 | 2 | 6 | 3 | 3 | 2 | 3 |
| Nuclear Periphery | 1 | 0 | 0 | 0 | 0 | 0 | 0 | – | 1 | 0 | 2 | 1 | 0 | 0 | 0 | 0 | 0 | 0 | 1 | 0 | 0 | 0 | 2 | 3 |
| Nucleolus | 0 | 0 | 0 | 0 | 0 | 0 | 0 | – | 0 | 0 | 0 | 0 | 0 | 0 | 0 | 4 | 3 | 0 | 0 | 0 | 0 | 0 | 0 | 0 |
| Peroxisomes | 0 | 0 | 0 | 0 | 0 | 0 | 0 | – | 0 | 0 | 0 | 0 | 0 | 0 | 0 | 0 | 0 | 0 | 0 | 0 | 0 | 0 | 0 | 1 |
| SpindlePole | 0 | 0 | 0 | 0 | 0 | 0 | 1 | – | 1 | 0 | 1 | 1 | 0 | 0 | 0 | 2 | 5 | 1 | 1 | 0 | 1 | 0 | 7 | 18 |
| Vac/Vac Membrane | 14 | 0 | 16 | 22 | 53 | 25 | 138 | – | 103 | 92 | 143 | 100 | 2 | 10 | 16 | 43 | 41 | 24 | 2 | 1 | 2 | 3 | 5 | 11 |
| Unique Cell Count | 520 | 165 | 297 | 276 | 327 | 374 | 575 | 457 | 441 | 618 | 520 | 485 | 530 | 719 | 149 | 153 | 109 | 521 | 168 | 298 | 349 | 622 | 626 | |
| Labelled Cell Count | 532 | 165 | 313 | 288 | 349 | 402 | 613 | 498 | 490 | 677 | 584 | 492 | 539 | 731 | 196 | 182 | 132 | 521 | 168 | 298 | 349 | 622 | 626 | |
Yeast GFP Assignment
Protein Abundance
| Screen | WT1 | WT2 | WT3 | RAP60 | RAP140 | RAP220 | RAP300 | RAP380 | RAP460 | RAP540 | RAP620 | RAP700 | HU80 | HU120 | HU160 | rpd3Δ_1 | rpd3Δ_2 | rpd3Δ_3 | AF100 | AF140 | AF180 |
|---|---|---|---|---|---|---|---|---|---|---|---|---|---|---|---|---|---|---|---|---|---|
| Mean Cell GFP Intensity (1e-4) | 10.0 | 10.1 | 9.6 | 9.1 | 10.1 | 6.9 | 8.9 | – | 7.3 | 8.3 | 7.7 | 7.8 | 10.7 | 10.0 | 10.1 | 11.6 | 11.7 | 11.8 | 9.1 | 9.3 | 9.3 |
| Std Deviation (1e-4) | 1.5 | 1.9 | 1.4 | 1.4 | 1.5 | 1.5 | 1.5 | – | 1.8 | 1.5 | 1.4 | 1.4 | 1.8 | 1.6 | 1.4 | 1.8 | 2.1 | 1.7 | 1.3 | 1.5 | 1.6 |
| Intensity Change (Log2) | – | – | – | -0.07 | 0.08 | -0.47 | -0.12 | – | -0.4 | -0.21 | -0.32 | -0.3 | 0.15 | 0.06 | 0.07 | 0.27 | 0.28 | 0.3 | -0.07 | -0.05 | -0.05 |
Localization Change
| Localization | RAP60 | RAP140 | RAP220 | RAP300 | RAP380 | RAP460 | RAP540 | RAP620 | RAP700 | HU80 | HU120 | HU160 | rpd3Δ_1 | rpd3Δ_2 | rpd3Δ_3 |
|---|---|---|---|---|---|---|---|---|---|---|---|---|---|---|---|
| Cortical Patches | 0 | 0 | 0 | 0 | – | 0 | 0 | 0 | 0 | 0 | 0 | 0 | 0 | 0 | 0 |
| Bud | 0 | 0 | 0 | 0 | – | 0 | 0 | 0 | 0 | 0 | 0 | 0 | 0 | 0 | 0 |
| Bud Neck | 0 | 0 | 0 | 0 | – | 0 | 0 | 0 | 0 | 0 | 0 | 0 | 0 | 0 | 0 |
| Bud Site | 0 | 0 | 0 | 0 | – | 0 | 0 | 0 | 0 | 0 | 0 | 0 | 0 | 0 | 0 |
| Cell Periphery | 0 | 0 | 0 | 0 | – | 0 | 1.8 | 0 | 1.9 | 0 | 0 | 0 | 0 | 0 | 0 |
| Cytoplasm | -1.9 | -4.0 | -3.8 | -7.9 | – | -9.7 | -8.2 | -10.2 | -10.6 | 2.3 | 2.0 | 2.3 | -7.0 | -6.2 | -4.9 |
| Endoplasmic Reticulum | 0 | 0 | 0 | 0 | – | 0 | 0 | 0 | 1.1 | 0 | 0 | 0 | 0 | 0 | 0 |
| Endosome | 0 | 0 | 0 | 0 | – | 0 | 0 | 0 | 0 | 0 | 0 | 0 | 0 | 0 | 0 |
| Golgi | 0 | 0 | 0 | 0 | – | 0 | 0 | 0 | 0 | 0 | 0 | 0 | 0 | 0 | 0 |
| Mitochondria | 0 | 0 | 5.2 | 0 | – | 6.1 | 5.7 | 6.8 | 7.6 | 0 | 0 | 0 | 0 | 0 | 0 |
| Nucleus | 0 | 0 | 0 | 2.0 | – | 3.3 | 0 | 3.1 | 3.2 | 0 | 0 | 0 | 0 | 0 | 0 |
| Nuclear Periphery | 0 | 0 | 0 | 0 | – | 0 | 0 | 0 | 0 | 0 | 0 | 0 | 0 | 0 | 0 |
| Nucleolus | 0 | 0 | 0 | 0 | – | 0 | 0 | 0 | 0 | 0 | 0 | 0 | 0 | 0 | 0 |
| Peroxisomes | 0 | 0 | 0 | 0 | – | 0 | 0 | 0 | 0 | 0 | 0 | 0 | 0 | 0 | 0 |
| SpindlePole | 0 | 0 | 0 | 0 | – | 0 | 0 | 0 | 0 | 0 | 0 | 0 | 0 | 0 | 0 |
| Vacuole | 1.2 | 4.3 | 0.7 | 6.8 | – | 6.3 | 5.8 | 6.6 | 5.5 | -4.5 | -2.8 | -2.6 | 6.9 | 6.5 | 5.0 |
External localization resources
Images






























Protein Concentration and Protein Localization Data
| R1 | R2 | R3 | ||||||||||||||||
|---|---|---|---|---|---|---|---|---|---|---|---|---|---|---|---|---|---|---|
| G1 Pre-START | G1 Post-START | S/G2 | Metaphase | Anaphase | Telophase | G1 Pre-START | G1 Post-START | S/G2 | Metaphase | Anaphase | Telophase | G1 Pre-START | G1 Post-START | S/G2 | Metaphase | Anaphase | Telophase | |
| Concentration | 4.5132 | 6.5219 | 5.8415 | 4.9497 | 4.8326 | 5.5686 | 7.0743 | 9.5283 | 9.0055 | 8.2337 | 8.0293 | 8.2483 | 7.4551 | 10.181 | 9.3164 | 8.7496 | 9.2251 | 9.1999 |
| Actin | 0.0104 | 0.0003 | 0.0031 | 0.004 | 0.0128 | 0.002 | 0.0053 | 0.0003 | 0.0002 | 0.0137 | 0.0024 | 0.0014 | 0.0602 | 0.0005 | 0.0042 | 0.0825 | 0.0254 | 0.0041 |
| Bud | 0.0011 | 0.0004 | 0.0002 | 0.0002 | 0.0004 | 0.0003 | 0.0006 | 0.0002 | 0.0001 | 0.0005 | 0.0003 | 0.0001 | 0.0023 | 0.0001 | 0.0007 | 0.0008 | 0.0006 | 0.0002 |
| Bud Neck | 0.0062 | 0.0003 | 0.0008 | 0.001 | 0.0025 | 0.0017 | 0.0011 | 0.0004 | 0.0004 | 0.0037 | 0.0016 | 0.0015 | 0.0011 | 0.0002 | 0.0003 | 0.0013 | 0.0011 | 0.0011 |
| Bud Periphery | 0.0013 | 0.0002 | 0.0001 | 0.0001 | 0.0007 | 0.0003 | 0.0003 | 0 | 0 | 0.0006 | 0.0004 | 0.0001 | 0.0025 | 0 | 0.0005 | 0.0008 | 0.0004 | 0.0001 |
| Bud Site | 0.0038 | 0.0021 | 0.0004 | 0.0018 | 0.0005 | 0.0003 | 0.0006 | 0.0006 | 0.0001 | 0.0005 | 0.0013 | 0.0001 | 0.0021 | 0.0003 | 0.0003 | 0.0093 | 0.0018 | 0.0001 |
| Cell Periphery | 0.0003 | 0.0001 | 0.0001 | 0.0001 | 0.0001 | 0 | 0.0001 | 0 | 0 | 0.0001 | 0.0001 | 0 | 0.0002 | 0.0001 | 0 | 0.0004 | 0.0001 | 0.0001 |
| Cytoplasm | 0.8526 | 0.9401 | 0.8995 | 0.8872 | 0.8444 | 0.8968 | 0.867 | 0.9464 | 0.9308 | 0.8738 | 0.8512 | 0.8839 | 0.7788 | 0.9816 | 0.9227 | 0.7066 | 0.8783 | 0.9187 |
| Cytoplasmic Foci | 0.0108 | 0.002 | 0.0027 | 0.0039 | 0.0076 | 0.0066 | 0.008 | 0.0024 | 0.0019 | 0.0027 | 0.0049 | 0.0081 | 0.0428 | 0.0009 | 0.013 | 0.0384 | 0.014 | 0.0055 |
| Eisosomes | 0.0001 | 0 | 0 | 0 | 0.0002 | 0 | 0.0001 | 0 | 0 | 0 | 0.0001 | 0 | 0.0003 | 0 | 0 | 0.0003 | 0.0001 | 0 |
| Endoplasmic Reticulum | 0.0051 | 0.0021 | 0.0023 | 0.0065 | 0.0046 | 0.0038 | 0.0053 | 0.0012 | 0.0009 | 0.0022 | 0.0032 | 0.0022 | 0.0082 | 0.0021 | 0.0014 | 0.0042 | 0.0044 | 0.0019 |
| Endosome | 0.0164 | 0.0018 | 0.0036 | 0.005 | 0.0283 | 0.0079 | 0.0135 | 0.001 | 0.0007 | 0.003 | 0.0154 | 0.006 | 0.0228 | 0.0002 | 0.0038 | 0.0682 | 0.0236 | 0.0104 |
| Golgi | 0.0033 | 0.0001 | 0.0014 | 0.0005 | 0.0036 | 0.0012 | 0.0019 | 0.0001 | 0 | 0.0006 | 0.0014 | 0.0006 | 0.0076 | 0 | 0.0026 | 0.0184 | 0.0087 | 0.0042 |
| Lipid Particles | 0.0062 | 0 | 0.0052 | 0.0002 | 0.0088 | 0.0005 | 0.0012 | 0 | 0 | 0.0001 | 0.0018 | 0.0002 | 0.0073 | 0 | 0.0002 | 0.0116 | 0.0088 | 0.0085 |
| Mitochondria | 0.0091 | 0.0002 | 0.0074 | 0.0007 | 0.0032 | 0.0009 | 0.0021 | 0.0002 | 0.0001 | 0.0013 | 0.0015 | 0.0005 | 0.0105 | 0.0001 | 0.0056 | 0.0042 | 0.0011 | 0.0042 |
| None | 0.0152 | 0.0037 | 0.0024 | 0.0065 | 0.0127 | 0.0032 | 0.0127 | 0.0027 | 0.0037 | 0.0052 | 0.0077 | 0.0052 | 0.0203 | 0.0075 | 0.0157 | 0.0029 | 0.0045 | 0.0023 |
| Nuclear Periphery | 0.0123 | 0.004 | 0.0039 | 0.0078 | 0.021 | 0.0062 | 0.0099 | 0.0026 | 0.0024 | 0.005 | 0.0171 | 0.0055 | 0.0053 | 0.0005 | 0.0015 | 0.0022 | 0.0046 | 0.0043 |
| Nucleolus | 0.0004 | 0.0001 | 0.0001 | 0.0002 | 0.006 | 0.0001 | 0.0002 | 0 | 0 | 0.0001 | 0.0033 | 0.0001 | 0.003 | 0 | 0 | 0.0003 | 0.0002 | 0.0007 |
| Nucleus | 0.0338 | 0.0403 | 0.0619 | 0.0701 | 0.0248 | 0.0552 | 0.0635 | 0.0397 | 0.0563 | 0.0836 | 0.0639 | 0.0796 | 0.0129 | 0.0057 | 0.0176 | 0.0112 | 0.0141 | 0.0293 |
| Peroxisomes | 0.0048 | 0 | 0.0023 | 0.0002 | 0.003 | 0.0048 | 0.0012 | 0.0001 | 0 | 0.0002 | 0.0004 | 0.0006 | 0.0063 | 0 | 0.0084 | 0.0289 | 0.002 | 0.0007 |
| Punctate Nuclear | 0.003 | 0.001 | 0.0017 | 0.0029 | 0.0114 | 0.0067 | 0.0031 | 0.0014 | 0.0016 | 0.0017 | 0.0182 | 0.0031 | 0.0033 | 0.0001 | 0.0009 | 0.0023 | 0.0049 | 0.0018 |
| Vacuole | 0.0028 | 0.0011 | 0.0007 | 0.001 | 0.0018 | 0.0012 | 0.0017 | 0.0005 | 0.0003 | 0.001 | 0.0029 | 0.0008 | 0.0012 | 0.0002 | 0.0003 | 0.0044 | 0.001 | 0.0008 |
| Vacuole Periphery | 0.0011 | 0.0002 | 0.0003 | 0.0003 | 0.0017 | 0.0004 | 0.0007 | 0.0001 | 0.0001 | 0.0003 | 0.0009 | 0.0002 | 0.0009 | 0 | 0.0001 | 0.0009 | 0.0004 | 0.001 |
Sequencing Data
| R1 | R2 | |||||||||
|---|---|---|---|---|---|---|---|---|---|---|
| G1 Post-START | S/G2 | Metaphase | Anaphase | Telophase | G1 Post-START | S/G2 | Metaphase | Anaphase | Telophase | |
| Gene Expression | 34.5449 | 52.6794 | 16.1753 | 30.853 | 28.9811 | 24.3711 | 43.1623 | 48.9659 | 33.6484 | 39.2164 |
| Translational Efficiency | 1.0713 | 0.9722 | 2.1414 | 0.7894 | 1.145 | 1.6927 | 1.7307 | 0.9683 | 1.4466 | 1.0809 |
Hit Data
| Dataset | Hit |
|---|---|
| Protein Concentration | ✔ |
| Protein Localization | ✘ |
| Gene Expression | ✘ |
| Translational Efficiency | ✘ |
Endocytosis
| Temp | Actin Patch (Sac6-tdTomato) | Cortical Patch (Sla1-GFP) | Late Endosome (Snf7-GFP) | Vacuole (Vph1-GFP) |
|---|---|---|---|---|
| 37℃ | ||||
| RT |
Cell Cycle Omics
CYCLoPs (Ykl069w-GFP)
| Gene / Allele | Actin Patch (Sac6-tdTomato) | Cortical Patch (Sla1-GFP) | Late Endosome (Snf7-GFP) | Vacuole (Sac6-tdTomato) |
|---|
| Gene | Images |
|---|
| Gene | Images |
|---|
Images are not yet available
Images are not yet available